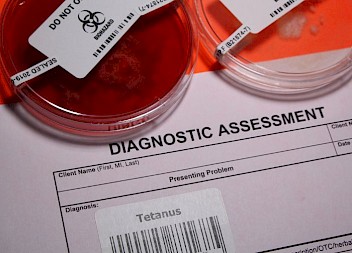
Family Compensated After Elderly Lady Died from Tetanus

The daughter of an 81-year-old man who died from complications of multiple rib fractures was awarded £16,000 compensation.
The deceased ‘D’ had fallen three times at both a respite care home and in hospital, resulting in multiple rib fractures. He developed haemo-pneumothorax, where blood and air enter the chest wall surrounding the lungs, and sadly died in June 2022.
His daughter was supported by Kelly Hunt of Medical Solicitors to bring a medical negligence claim on behalf of her late father’s estate.
Case summary
In early May 2022, D was taken to hospital following a fall at a care home. A falls risk assessment was undertaken which recommended that D use a walking stick and have assistance when moving around the ward. He was given a call buzzer but a nurse was unsure whether he had the capacity to use it so he was placed in a bed opposite the nurses’ station.
Over a week later, D fell in the early hours having sat on the edge of the bed and slipped off. The falls risk assessment was updated with falls risk-reducing actions in place, including being nursed on a low bed, having one-to-one nursing, wearing non-slip socks, and having a call buzzer at hand.
A few days later, he fell a second time having slipped out of a chair. He was with a nurse at the time of the fall and no apparent injury was sustained. The falls risk assessment was updated, and it was noted that the physiotherapists had advised to keep the walking frame away from D until he needed to use it.
D fell a third time a couple of days later at 6.15am, but this one was unwitnessed. The ward was understaffed on a twilight shift and there was an increased number of patients needing enhanced supervision, meaning staff had been unable to provide one-to-one support since 1am. D had attempted to go to the toilet by himself and fell, banging his head. He also complained of pain in his upper ribs.
A patient in the next bed reported that D had fallen through the curtain, onto him/the bed and then onto the floor.
No patient checks had been recorded since 1am due to staffing numbers, although nurses insisted that they had completed their rounds despite paperwork not being done.
D’s falls risk assessment was updated and the family were informed.
A CT head scan showed no bleed or fracture. An initial chest x-ray showed mildly displaced fractures to two ribs, with overlying surgical emphysema. It also showed blood and air were present in his chest.
The fractured ribs and Haemo-pneumothorax contributed to his death on 3rd June 2022.
Litigation
A ‘Serious Incident Report’ noted that whilst D had been assessed as requiring specialling care continually since 5 May 2022, this had not been routinely followed.
The parties engaged in the pre-action protocol process and the Defendant Trust admitted a failure to take adequate steps to prevent the unwitnessed fall on 15/05/2022. It was further admitted that, with adequate measures in place, on the balance of probability, the fall would have been avoided, and that the adverse effects of the fracture and underlying lung damage on respiratory function, materially contributed to death.
The claim settled in October 2023 for £16,000 which included £13,000 general damages and £3,000 funeral expenses.